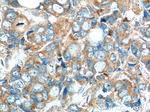
C7orf47 Antibody in Immunohistochemistry (Paraffin) (IHC (P))

Search
Proteintech
C7orf47 Polyclonal Antibody
{{$productOrderCtrl.translations['antibody.pdp.commerceCard.promotion.promotions']}}
{{$productOrderCtrl.translations['antibody.pdp.commerceCard.promotion.viewpromo']}}
{{$productOrderCtrl.translations['antibody.pdp.commerceCard.promotion.promocode']}}: {{promo.promoCode}} {{promo.promoTitle}} {{promo.promoDescription}}. {{$productOrderCtrl.translations['antibody.pdp.commerceCard.promotion.learnmore']}}
产品信息
24214-1-AP
种属反应
已发表种属
宿主/亚型
分类
类型
抗原
偶联物
形式
浓度
规格
纯化类型
保存液
内含物
保存条件
运输条件
产品详细信息
Immunogen sequence: ESELKSADG EEAAAVPGPP PEPQVPQLRA PVPEPGLDLS LSPRPDSPQP RHGSPGRRKG RAERRGAARQ RRQVRFRLTP PSPVRSEPQP AVPQELEMPV LKSSLALGLE LRAAAGSHFD AAKAVEEQLR KSFQIRCGLE ESVSEGLNVP RSKRLFRDLV SLQVPEEQVL NAALREKLAL LPPQARAPHP KEPPGPGPDM TILCDPETLF YESPHLTLDG LPPLRLQLRP RPSEDTFLMH RTLRRWEA (7-253 aa encoded by BC026269)
靶标信息
Inhibits PPP1CA phosphatase activity. [UniProt]
仅用于科研。不用于诊断过程。未经明确授权不得转售。
生物信息学
蛋白别名: Protein phosphatase 1 regulatory subunit 35; UPF0683 protein C7orf47
基因别名: C7orf47; PPP1R35
UniProt ID: (Human) Q8TAP8
Entrez Gene ID: (Human) 221908